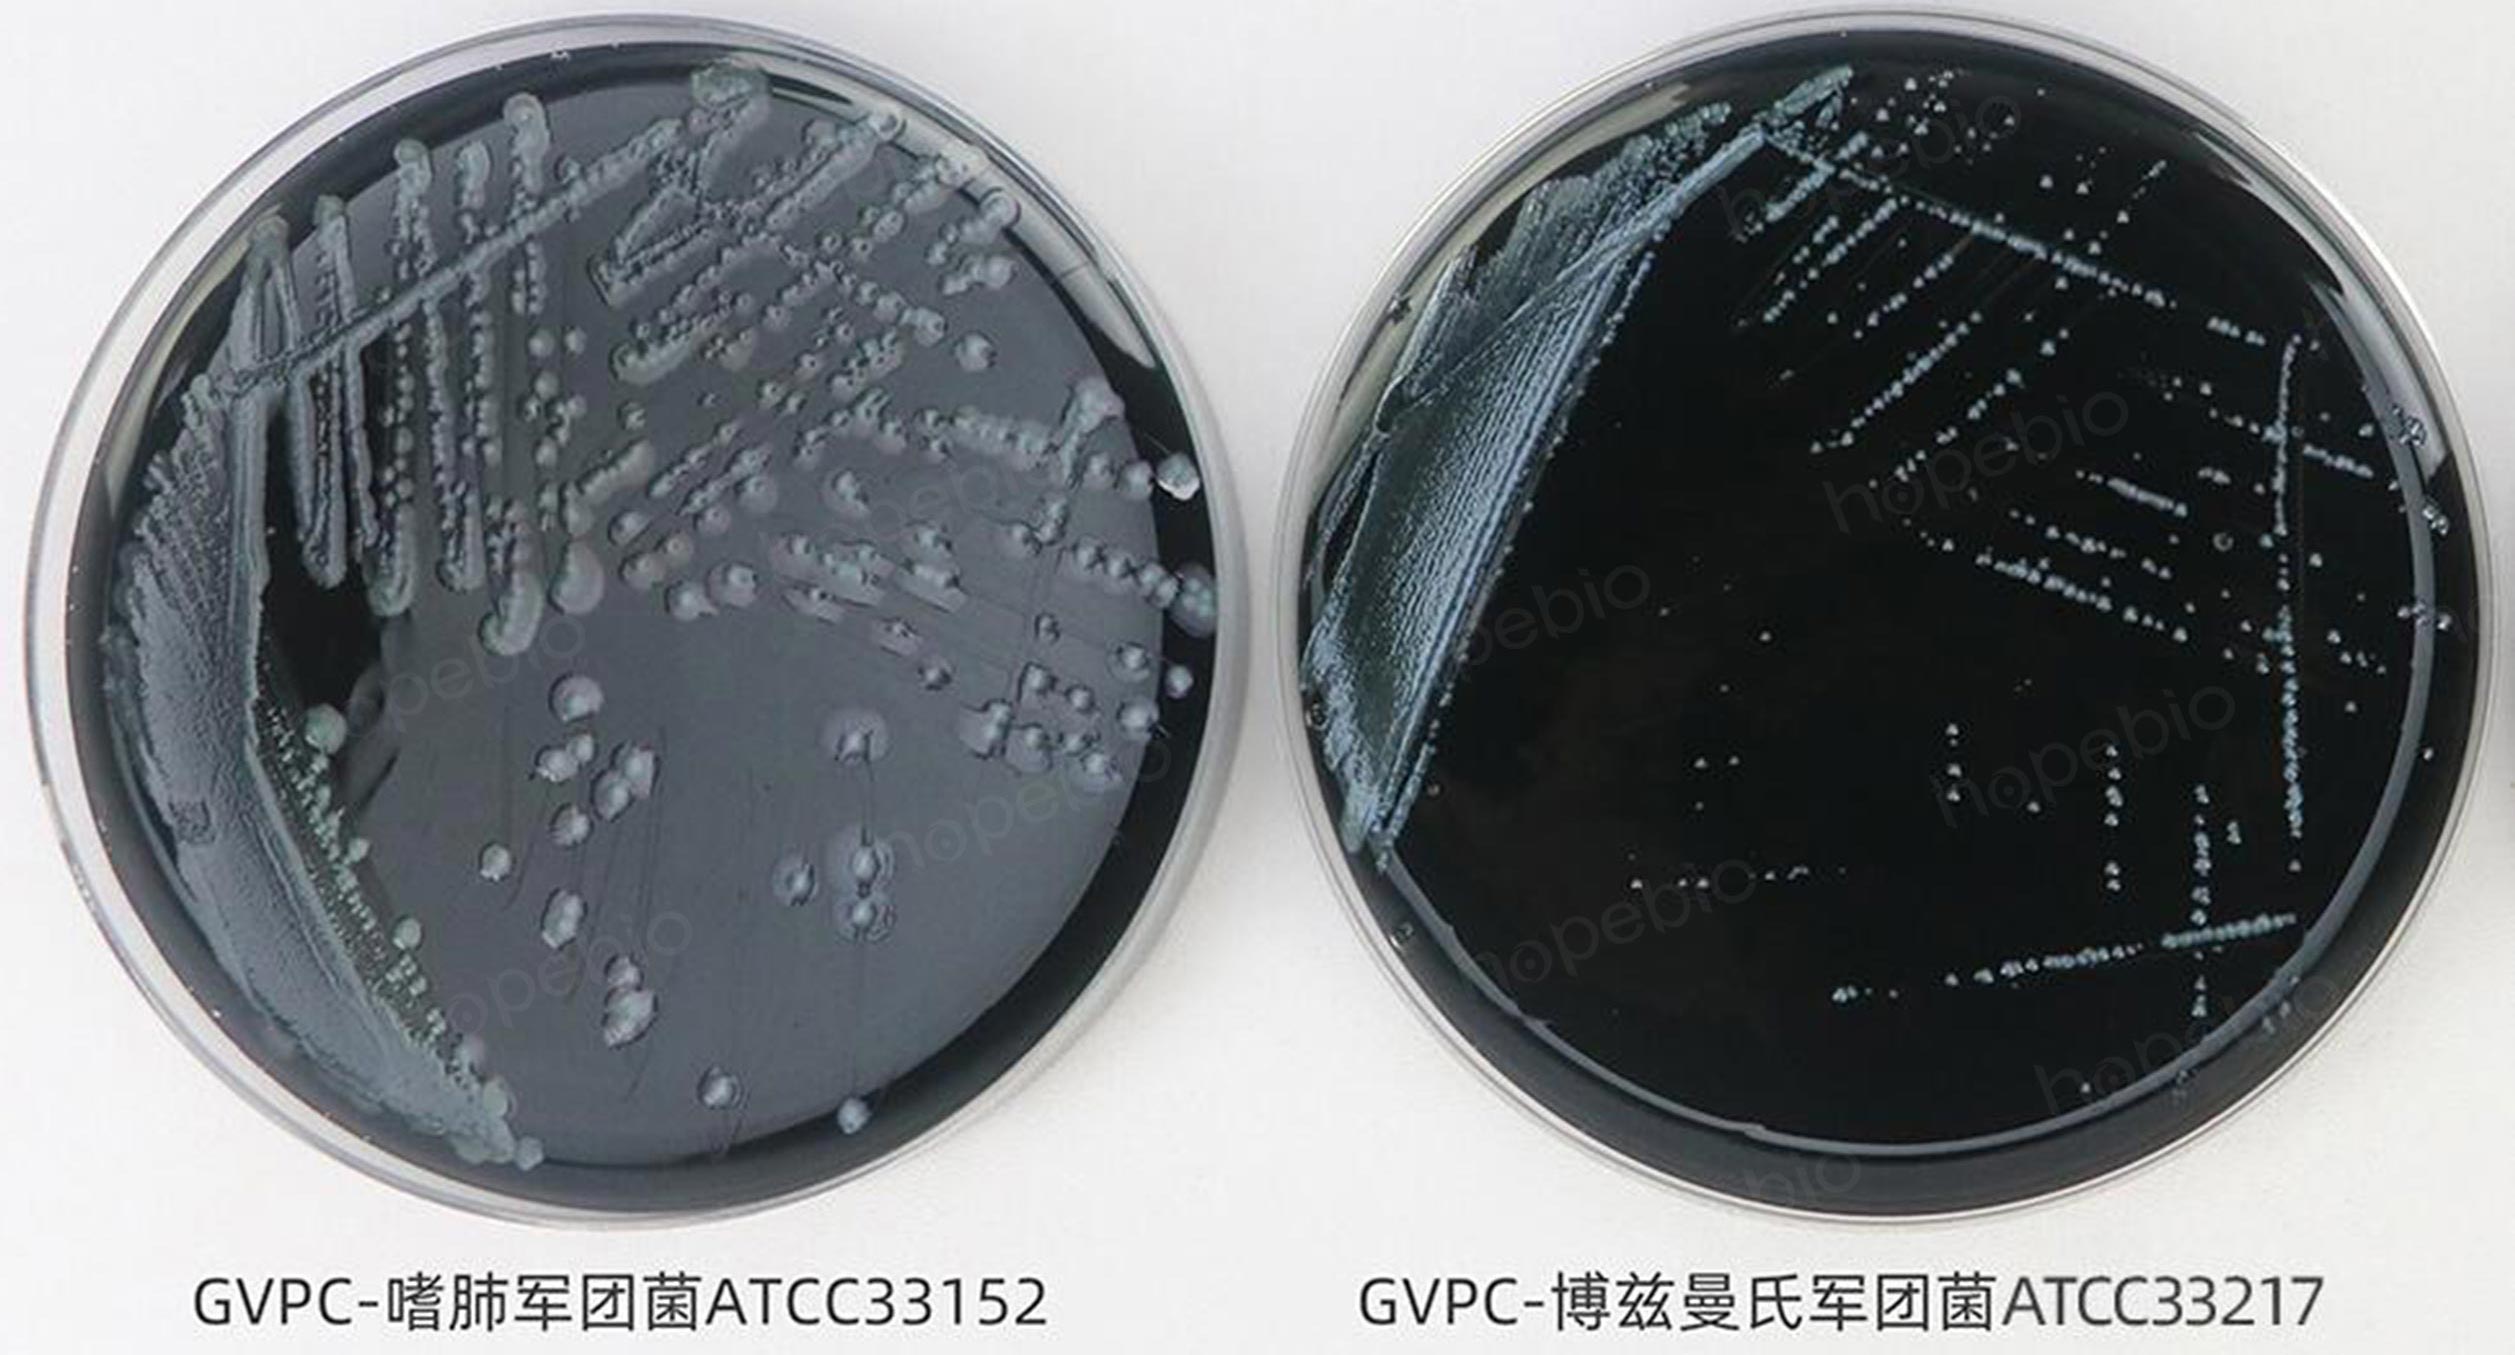

用途:用于军团菌的分离培养(GB/T 18204.5-2025标准)。
添加剂:
每瓶需配套添加24盒HB8496a GVPC添加剂使用,每100ml GVPC琼脂基础需添加1盒HB8496a GVPC添加剂。
成分(g/L)
|
酵母浸粉
|
10.0
|
|
ACES缓冲液
|
10.0
|
|
活性炭
|
2.0
|
|
可溶性焦磷酸铁
|
0.25
|
|
α-酮戊二酸单钾盐
|
0.4
|
|
氢氧化钾
|
2.8
|
|
琼脂
|
15.0
|
|
pH值6.8±0.2
|
25℃
|
用法:
称取本品40.45g,加热溶解于1000ml蒸馏水中,分装三角瓶,每瓶100ml,121℃高压灭菌15分钟,冷至50℃左右时,加入1套GVPC琼脂添加剂,混匀,倾入无菌平皿。
添加剂成分(100ml培养基):
甘氨酸0.3g、万古霉素0.1mg、多粘菌素B 7920U、放线菌酮8mg、盐酸半胱氨酸0.04g。
注:加入添加剂后若pH值不正确,可用KOH进行调整。
注:培养基中含不溶性活性炭,整体培养基呈黑色。
GVPC琼脂/BCYE琼脂培养基/BCYE-Cys琼脂微生物质控结果:
GVPC平板上嗜肺军团菌及博兹曼军团菌生长(培养至72h)

BCYE平板上的嗜肺军团菌、博兹曼军团菌(培养至72h)和大肠埃希氏菌(培养24h)
BCYE-CYS平板上的嗜肺军团菌、博兹曼军团菌(培养48h)和大肠埃希氏菌(培养24h)
因GVPC琼脂培养基和BCYE培养基本身不具有显色功能,导致杂菌与军团菌的菌落特征上不好区分,但可以通过培养时间及BCYE-cys进行排除,48h内形成大菌落的均不是军团菌,BCYE-Cys上能生长的均不是军团菌。
GVPC琼脂(GB/T 18204.5标准)微生物灵敏度试验:
按标签用法制备培养基,接种以下质控菌株,放置36±1℃需氧培养72-168小时。
标准依据:
GB/T 18204.5-2025 公共场所卫生检验方法 第5部分集中空调通风系统